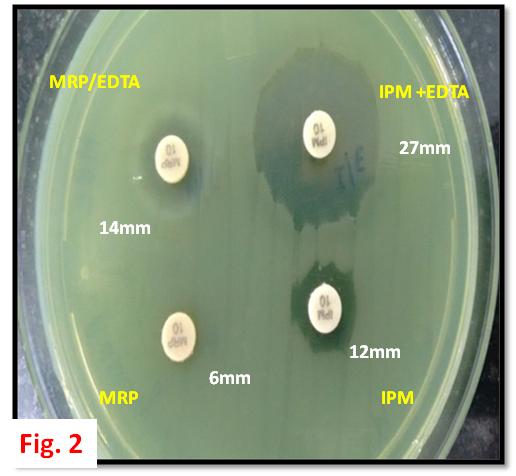
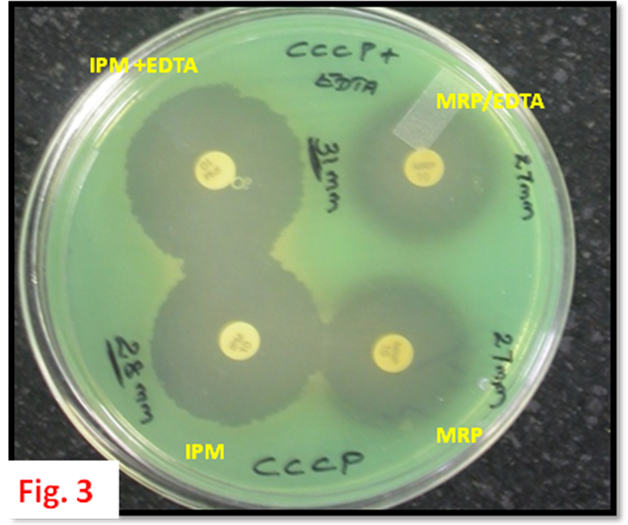
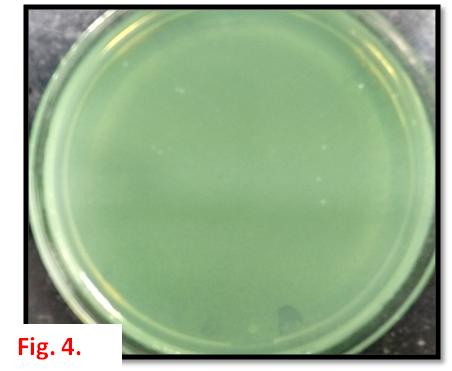

1Dept of Microbiology, L & T Microbiology Research Centre, Vision Research Foundation, Sankara Nethralaya, Chennai, Tamil Nadu, India 600006, 2School of Chemical & Biotechnology, SASTRA University, Thanjavur, Tamil Nadu, India 613401
Email: drjm@snmail.org
Received: 07 Jan 2015 Revised and Accepted: 20 Jun 2015
ABSTRACT
Objective: To standardize a method for the differential detection of Metallo Betalactamase (MBL) production and efflux pump mechanism using Carbonyl Cyanide 3-ChloroPhenylhydrazone (CCCP) among the clinical isolates of Pseudomonas aeruginosa recovered from ocular specimens.
Methods: A total of 110 clinical isolates of Pseudomonas aeruginosa were plated onto Muller-Hinton agar (MHA) plate with CCCP and without CCCP. Carbapenems-Ethylenediaminetetraacetic acid (EDTA) combination disk method was performed on CCCP± plates for individual isolates and the results were compared.
Results: Out of 110 clinical isolates of P aeruginosa studied, 11(10%) were tested positive for MBL Production by carbapenem-EDTA combination test/CCCP-test. In which, six isolates showed positive for both efflux and MBL production using CCCP+plate and 5 isolates showed positive only for MBL production.
Conclusion: The current study standardized a method for detecting both MBL and efflux mechanism in a single plate consists of CCCP± plate containing antibiotic disk with and without EDTA. Implication of this method in routine diagnostics will help the clinicians to treat the patient with appropriate drug choice and dosage.
Keywords: Antimicrobial resistance, Pseudomonas aeruginosa, Keratitis, Ocular infections, Efflux Pump mechanism, Metallo Betalactamases.
INTRODUCTION
Over the past three decades, Pseudomonas aeruginosa is on its way to becoming one of the most menacing nosocomial pathogen, causing and wide range of human infection especially among immune compromised status [1]. Keratitis is the most common ocular infection caused by P aeruginosa but may occasionally involve the intraocular cavity causing endophthalmitis a dreadful condition leads to blindness if left untreated. Emerging multi-drug-resistant (MDR) P aeruginosa infections increases the rate of mortality and morbidity due to treatment failure which extends hospital stay with high economic burden [2].
MDR strains producing metallo betalactamase enzymes encoded by blaVIM, IMP, KPC, NDM, confers primary mechanism for the drug resistance [3]. Albeit, the contribution of efflux pump mechanism in drug resistance is poorly studied. MDR strains with energy dependent transporter proteins can expel broad range of antibiotics and biocides from bacterial cell that confers reduced availability of antibiotics in infected sites, where the antibiotic concentrations are non-optimal which renders cross-resistance [4].
The clinical impact of efflux pump in the antimicrobial therapy is critical but, the focus on efflux mechanism is very rare or not at all diagnosed in routine laboratories and often masked by high-level resistance mechanisms [4].
Hence, the current study was undertaken to standardize a method for the differential detection of Metallo Betalactamase (MBL) and Efflux pump production in a single plate using Carbonyl Cyanide 3-Chlorophenyl hydrazone (CCCP) compound an oxidative phosphorylation uncoupler which, increases the susceptibility of a number of multidrug resistant bacteria by disrupting the proton pump particularly for meropenem drug [5].
The method standardized in the current study will help us to detect strains with efflux pump mechanism and MBL production concurrently using simple phenotypic method.
MATERIALS AND METHODS
Clinical strains
One hundred and ten ocular isolates of P. aeruginosa were isolated from 110 variety of specimens received for microbial culture at L & T Microbiology Research Centre, Kamalnayan Bajaj Research Centre, Sankara Nethralaya, a tertiary eye care center at Chennai, India was used for this study. Study protocol was approved by the institutional ethics sub-committee (IRB). Further identification and antibiotic susceptibility tests, ESBL and MBL detection were carried out as per our previous report [6].
Phenotypic detection method
Preparation of CCCP
Mueller Hinton Agar (MHA) plates were prepared by following protocol, appropriate MHA medium was weighed and dissolved in distilled water and subjected for autoclaving. To 100 ml of media 12.5µM CCCP was added after sterilization and media was poured into 5 individual plates separately and incubated overnight to check the sterility of the media prepared.
CCCP ± combination method for detection of MBL and Efflux mechanism
Each isolate was inoculated onto peptone water and inoculums was adjusted to 0.5McFarland standard and lawn culture was made onto MHA with CCCP designated as CCCP+ and without CCCP designated as CCCP-plates. Two sets of Imipenem (IMP) and Meropenem (MRP) disc were placed at 15 mm apart in both CCCP± plate and 5 µl of Ethylenediaminetetraacetic acid (EDTA) were placed over one set of the drugs. The plates were further incubated at 37 °C for 18-24 hours. The zone of inhibition was measured and interpreted.
RESULTS
The current study was carried out to detect the prevalence of carbapenems, efflux pump mechanism among ocular isolates of P aeruginosa MDR strains. Out of the 110 clinical isolates of P aeruginosa studied, 11(10%) were tested positive for MBL Production by Carbapenem- EDTA combination test/CCCP- test. Out of 11 isolates tested for Triple combination Method, 6 isolates showed positive for both efflux and MBL production and 5 isolates showed positive only for MBL.
Table 1: Interpretation criteria for CCCP± test
| Designation | Criteria |
| Both MBL and efflux pump producer | If the zone size around disks with added EDTA in CCCP+is≥5 mm larger than with EDTA in CCCP-. |
| MBL Positive | If the zone size produced by the disks with EDTA is ≥5 mm larger than without EDTA in CCCP- |
| Only Efflux producer | If the zone size produced by the disks without EDTA in CCCP+is ≥5 mm larger than with/without EDTA in CCCP-plate |
| Only MBL producer | If the zones size produced by the disks with EDTA in CCCP- and CCCP+ were same or±2 mm. |

Fig. 1: Protocol and interpretation guidelines in flow chart format for detection and differentiation of both MBL and Efflux pump mechanism simultaneously using CCCP± combination method
CCCP± combination method
This novel method containing 2.5 µM CCCP in MHA medium tested positive for 6 isolates and mainly inhibition zone around the meropenem (MRP) disk with and without EDTA showed comparatively larger zone than in the CCCP-test. Zone of inhibition are shown in the Table.1. Except M2271/13 isolate which showed increased zone size in imipenem disk with and without EDTA in CCCP+ other isolates showed no significant change of zone size for imipenem drug.
Fig. 2: Combination disk method/CCCP-plate for MBL detection. Result showing inhibition zone for M2271/13 isolate around the IPM+EDTA disk is 27 mm which is apparently larger than that around the IPM disk (12 mm), indicating MBL production. Comparable result is obtained with MRP disk (6 mm) and MRP+EDTA disk is 14 mm of zone size observed. Abbreviations: IPM, Imipenem (10 µg); IPM+EDTA, Imipenem (10 µg)+5 µl 0.5M EDTA; MRP, Meropenem (10 µg); MRP+EDTA, Meropenem (10 µg)+5 µl 0.5M EDTA
Fig. 3: CCCP± combination method for MBL and Efflux pump detection. Result showing inhibition zone for M2271/13 isolate containing 2.5 µM CCCP+MHA medium (CCCP+). The inhibition zone around the MRP (27 mm) and MRP+EDTA disk (27 mm) is apparently same for both the discs indicative of sole efflux pump production. And the inhibition zone around the IPM+EDTA disk (31 mm) is apparently larger than that around the IPM disk (28 mm) indicating both MBL and decreased efflux production against imipenem drug. Abbreviations: IPM, Imipenem (10 µg); IPM+EDTA, Imipenem (10 µg)+5 µl 0.5M EDTA; MRP, Meropenem (10 µg); MRP+EDTA, Meropenem (10 µg)+5 µl 0.5M EDTA
Out of 6 efflux positives isolates observed, 2 (1.8%) were from donor corneal rim, 2 (1.8%) from eviscerated material and each 1(0.9%) from corneal button and corneal scraping respectively (table 2; fig. 1-3). CCCP+ medium showed no inhibition of bacterial growth, as observed in control plate for confirmation of non-activity of CCCP as an antibacterial agent. P aeruginosa VRFPA08 exhibiting blaVIM-2, an MBL enzyme producing strain has been used as a positive control for phenotypic method [7].
Fig. 4: Control plate containing CCCP+MHA medium. The M2271/13 isolate has been used for negative control and screened for any activity of CCCP against P aeruginosa growth. Detected no activity. Which indicates CCCP act as efflux pump inhibitor only and has no bactericidal activity.
DISCUSSION
Since, there is no standard phenotypic confirmatory tests for MBL production, several primary screening methods for detection of MBL-producing organisms have been developed, mainly the EDTA combination disk diffusion method [8]. Many studies have reported using Phe-Arg-β-naphthyl amide (PAβN), a broad spectrum Efflux pump inhibitor (EPI) against various drugs for phenotypic detection of efflux mechanism [9]. But CCCP has been reported to have increased activity against meropenem substrate with 2-4 fold increased value of MIC [10, 11]. Hence, we used CCCP as EPI against MBL producing P aeruginosa MDR strains. Considering MIC test may require sophisticated equipments which may not be available in basic labs with minimal setup, whereas simple MHA plate based CCCP± method described in this study could be carried out in any basic laboratories.
Drug efflux pumps as another additional mechanism of resistance is being reported increasingly among a number of clinically-important bacteria, remarkably in Pseudomonas aeruginosa [12]. Admitting that high level resistance may not occur as a result of multidrug efflux pumps alone, the association of the efflux gene over expression among highly-resistant clinical isolates cannot be ignored [4]. Efflux pump inhibitors have been shown to reverse multidrug resistance in P aeruginosa and other bacteria [5]. The effects of these compounds, such as CCCP, on the antimicrobial susceptibility were examined in some studies [13, 14]. Rajamohan et al., found that addition of CCCP at final concentration of 25 μg/ml greatly reduced the MIC of various biocides from 2 to 12 folds [14]. We observed that the meropenem susceptibility of 6 isolates was increased in the presence of CCCP, mainly 2 to 4 folds in zone size. Imipenem susceptibility was increased in one isolate in the presence of CCCP in consistence with the results obtained by Pournaras, S et al. [11].
Further, we have standardized a method for detecting both MBL and efflux mechanism in a single plate consists of CCCP± containing antibiotic disk with and without EDTA for the evaluation of both MBL and efflux pump mechanism. Further, we have cross checked that there is no cross effect due to either EDTA or CCCP against bacterial growth using negative control of CCCP+ standard methods with triplicates of bacterial isolate used for the study showed in fig.3.
This novel method of detecting MBL and Efflux together can be used in any routine diagnostic labs in addition to MBL detection test. This method is inexpensive and can be used by technicians as interpretation does not require experts. Implication of this method in routine diagnostics will help the microbiologist to conclude a better antimicrobial susceptibility result. If the clinical isolate is found to be a producer of efflux pump mechanism, the clinician can be guided to take appropriate decision to increase the dosage of drug (s) used for the treatment that can avoid the decreased bioavailability on the infected site or any other alternative drug to be used. Decision of appropriate drug dosage and drug variant will aid in treating patient early as possible. To conclude a cost-effective reliable, reproducible phenotypic method for detecting both MBL and efflux mechanism concurrently was standardized.
Table 2: Shows Zone of inhibition size obtained for the isolates positive for both MBL and Efflux positive
| Isolate ID | Genome ID | Without CCCP-MBL Detection | With CCCP-MBL+Efflux Detection |
| Zone size in mm | MBL Result | ||
| IMP | MER | ||
| M2271/13 | JMNMN14 | 12 | 6 |
| M2227/13 | VRFPA04 | 15 | 6 |
| M2558/13 | JMNMN06 | 24 | 12 |
| M1178/13 | VRFPA03 | 14 | 10 |
| M2444/14 | JMNMN09 | 18 | 6 |
| M0028/14 | JMNMN10 | 16 | 12 |
| mean±SD | 16.5±4.18 | 8.67±3.01 | 26.5±1.52 |
Note: IMP-Imipenem; MER-Meropenem; EDTA-Ethylenediaminetetraacetic acid; CCCP-Carbonyl Cyanide 3-ChloroPhenylhydrazone, Pos-Positive. Data shown with individual zone of inhibition with over all mean±SD for the six positive results. mean±SD value of with CCCP and without CCCP produced statistically significant difference could be appreciated for all the drug groups except Imipenem with EDTA in both±CCCP plates.
Table 3: Shows distribution of MBL and Efflux positive results among ocular specimens identified by phenotypic methods
| S. No. | Specimen | Total No of Isolates | No of MBL positive | No of MBL+Efflux Positive |
| 1 | Donor Corneal Rim | 7 (6.36%) | 2 | 1 |
| 2 | Aqueous chamber Tap | 4(3.63%) | 0 | 0 |
| 3 | Corneal scraping | 34 (30.9%) | 4 | 2 |
| 4 | Conjuctival swab Donor Eye | 1 (0.9%) | 0 | 0 |
| 5 | Contact lens | 6 (5.45%) | 0 | 0 |
| 6 | Corneal button | 10 (9.09%) | 3 | 1 |
| 7 | Eviscerated material | 11(10.0%) | 2 | 2 |
| 8 | Vitreous aspirate | 11 (10.0%) | 0 | 0 |
| 9 | Conjuctival swab | 19 (17.27%) | 0 | 0 |
| 10 | Scleral scraping | 1 (0.9%) | 0 | 0 |
| 11 | Canalicular pus | 1 (0.9%) | 0 | 0 |
| 12 | Infective suture | 1 (0.9%) | 0 | 0 |
| 13 | Iris tissue | 1 (0.9%) | 0 | 0 |
| 14 | Bandage lens | 1 (0.9%) | 0 | 0 |
| 15 | Conjuctival scraping | 1 (0.9%) | 0 | 0 |
| 16 | Intra ocular lens | 1 (0.9%) | 0 | 0 |
| Total | 110 | 11 (10.0%) |
6 (6.6%) |
ACKNOWLEDGEMENT
We thank the Indian Council of Medical Research (ICMR), the funding agency, for their generous funding and support for the research work (project code AMR/10/2011-ECD-I).
CONFLICT OF INTERESTS
Declared None
REFERENCES